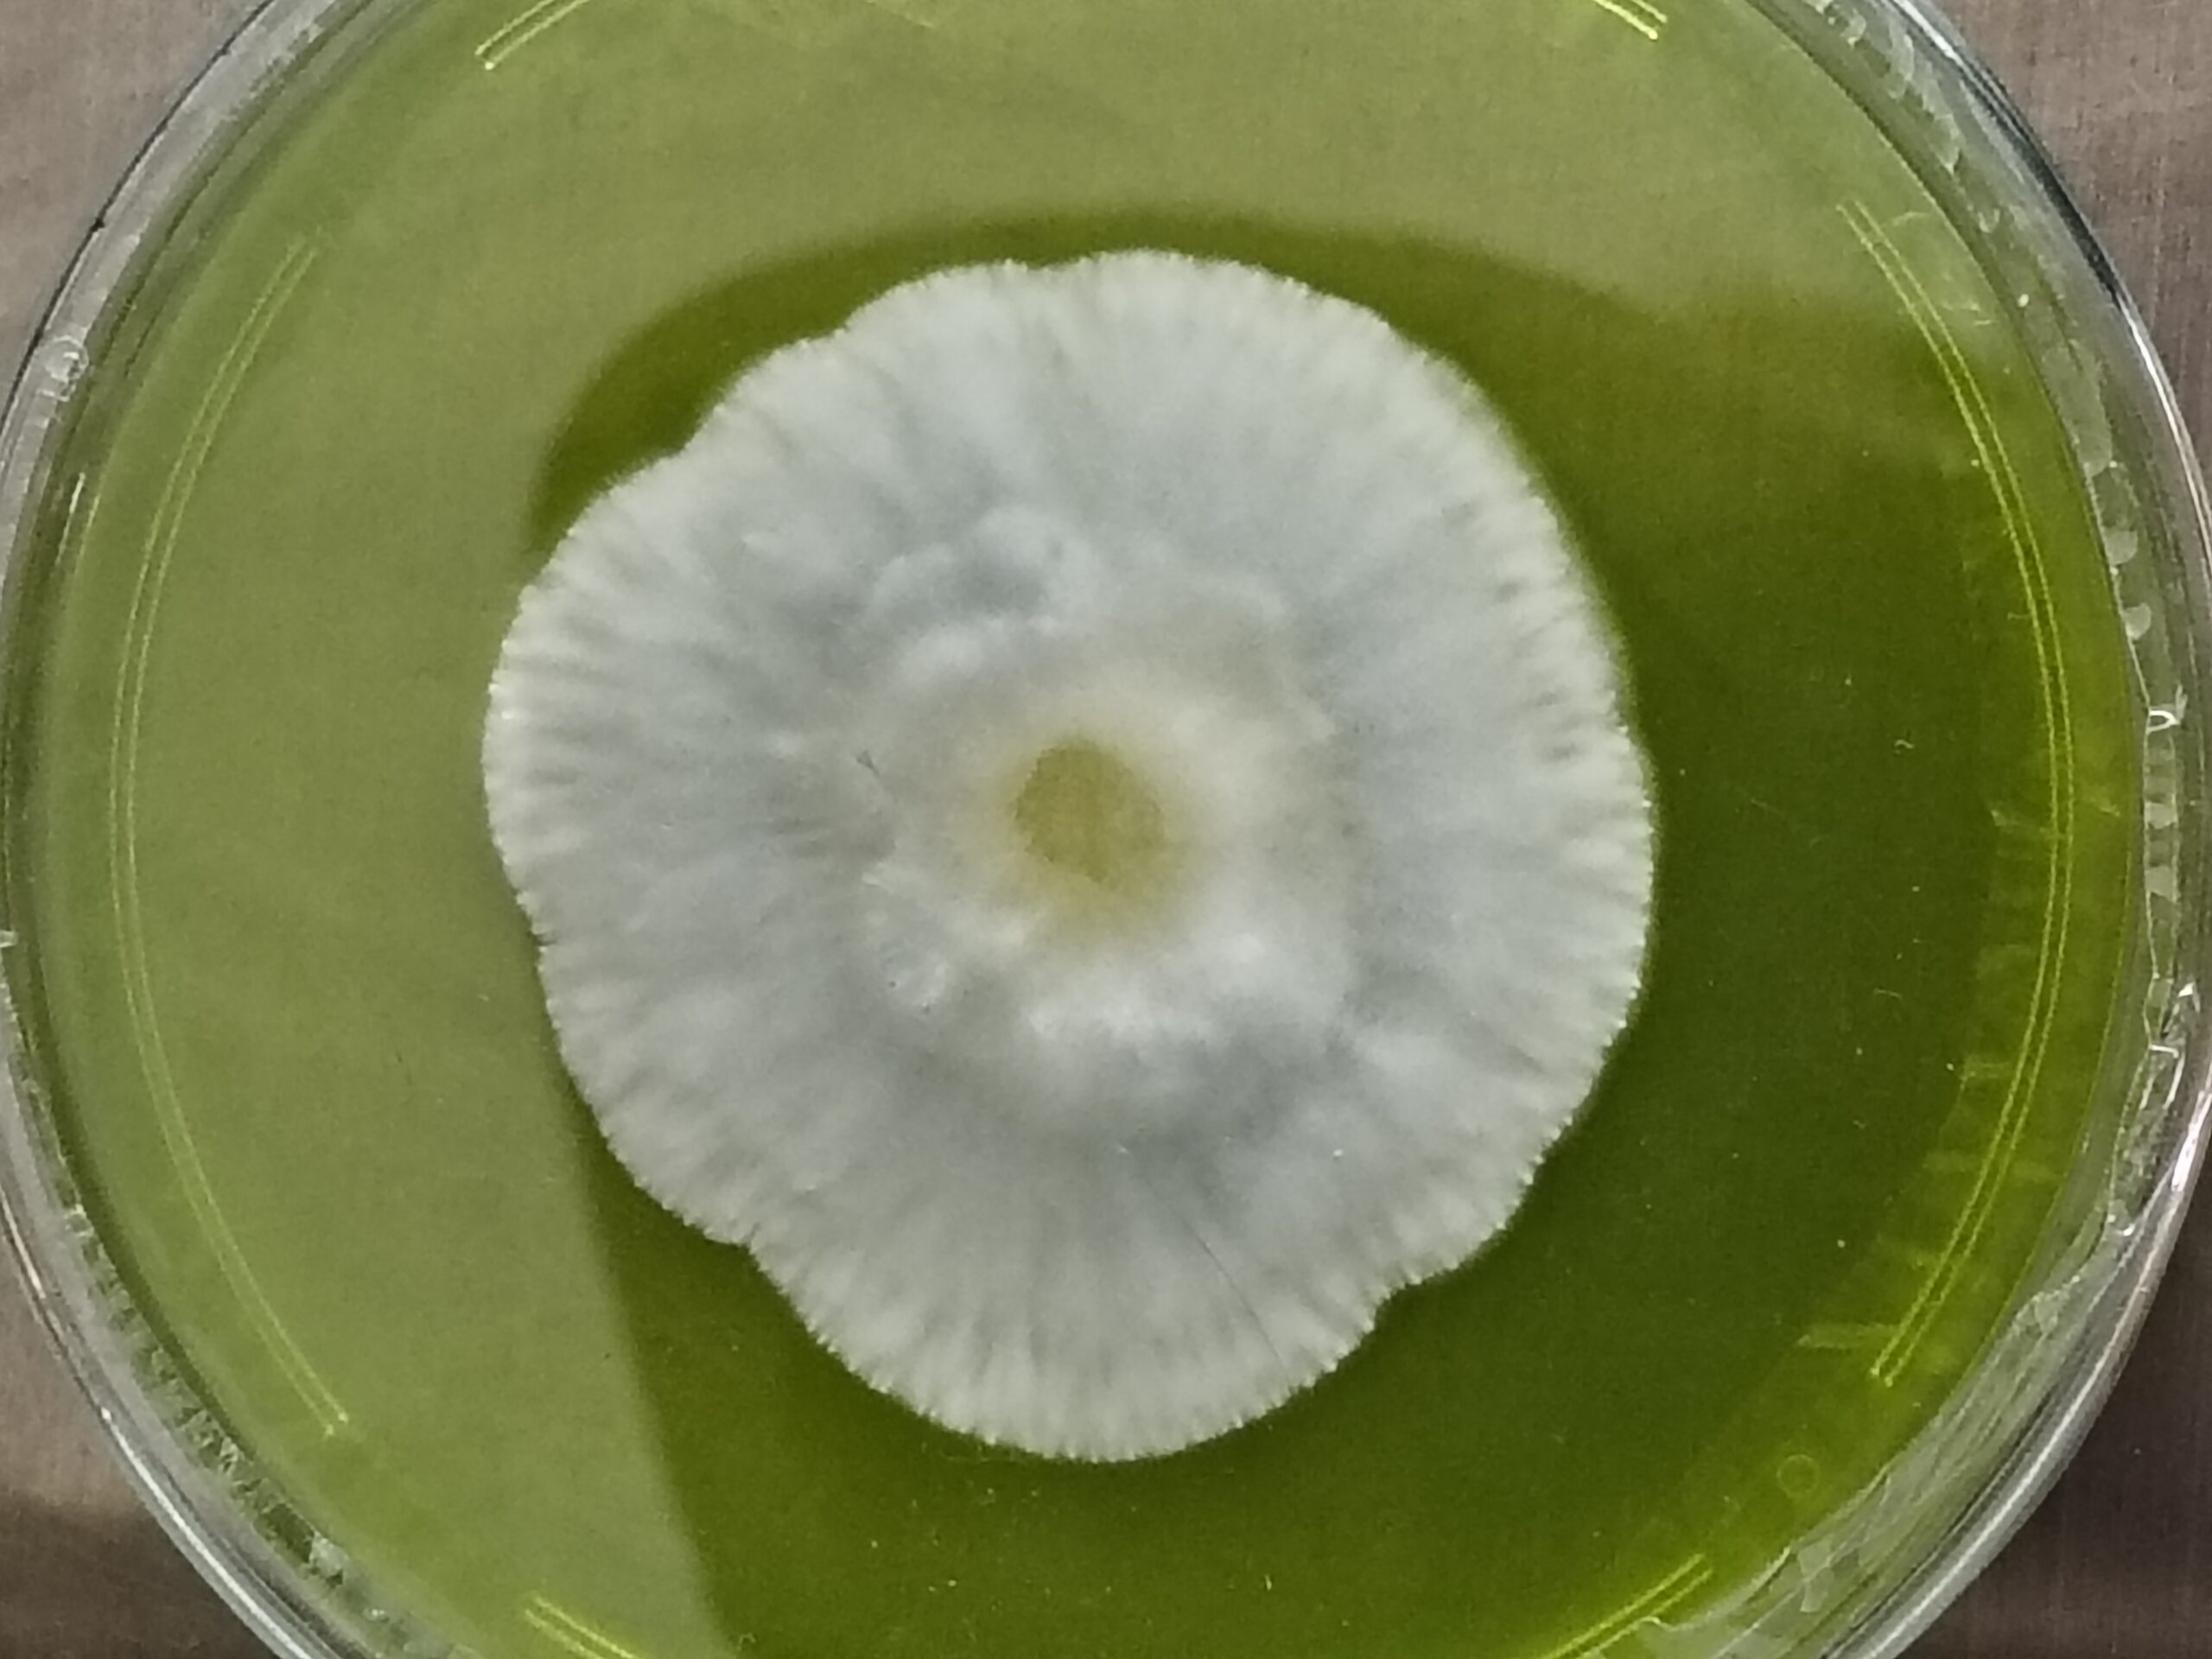

Only logged in customers who have purchased this product may leave a review.

Marvelous Mikes Fungal Forge
Winter Teacher (Psilocybe caeruleorhiza) Research Syringe
$25.00
The Local Legend has arrived at the Forge!
Forgers, it’s time to show some love for a hometown powerhouse. We’ve gone out into the elements to bring you the Winter Teacher. This isn’t a standard variety—this is a Wild Specimen sourced right here in Salem, Ohio.
While other genetics are hiding from the frost, this native wood-lover is at its peak. If you want to study raw, rugged vigor from a local survivor, this is the elite addition your library needs.
Why the Winter Teacher is a Must-Have:
Wild Salem, Ohio Genetics: Sourced from the wild right here in Salem. These genetics are “Ohio Strong”—built to thrive in the cold, surviving and fruiting from October through January.
The Blue Root: Famous for its intense, immediate bluing reaction (caeruleorhiza means “blue root”). It provides a stunning visual masterclass for tissue study.
Aggressive Morphology: These plates feature isolated, ropey rhizomorphic sectors. Expect lightning-fast expansion and thick, healthy mycelial mats that only wild-strength genetics can produce.
Rare Specimen: You won’t find this local Salem wild-type just anywhere. This is a rare opportunity to study a true North American native in plate form.
What You Get:
One (1) Fully Colonized Research Plate.
Parafilmed to ensure maximum freshness and zero contamination.
Wild-Sourced Isolates selected for high-vigor and clean growth patterns.
Forged with passion in Ohio. Fast shipping. Discrete packaging. Extreme quality.
Units Sold: 2
Shipping costs
| Shipping from | United States (US) |
| Within United States (US) | $8.00 |
National Shipping Details
| Minimum shipping charge per order | $8.00 |
| Maximum shipping charge per order | $8.00 |

Reviews
There are no reviews yet.